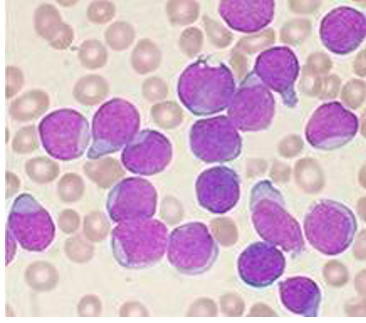

This tumour is from a 4 year old child contains a lobulated tan-white mass. What is the most likely name of the cancer? [1]

Wilms tumour
How does Wilms tumour present histologically? [1]
tumor shows attempts to form primitive glomerular and tubular structures. Pediatric neoplasms are often composed of cells that resemble primitive embryonic counterparts: -blasts. In this case the cells are reminiscent of developing nephroblasts.

Which is the main gene involved in high risk patients of neuroblastoma?
MYCN
WT1
ALK
PHOX2B
Which is the main gene involved in high risk patients of neuroblastoma?
MYCN
WT1
ALK
PHOX2B
Which is the main gene involved in hereditary patients of neuroblastoma?
MYCN
WT1
ALK
PHOX2B
Which is the main gene involved in hereditary patients of neuroblastoma?
MYCN
WT1
ALK
PHOX2B
Endometrial cancer is caused by an excess of which hormone?
progesterone
oestrogen
LH
FSH
Endometrial cancer is caused by an excess of which hormone?
progesterone
oestrogen
LH
FSH
What are oncogenes activated by? [4]
Activated by gain of function mutations:
- mutation
- chromosome translocation
- gene amplification
- retroviral insertion
What are tumour suppressor genes inactivated by? [3]
Inactivated by:
* mutations
* deletions
* DNA methylation (epigenetic)
How does Wilm tumour present? [3]
- Tumour of the kidney (aka nephroblastoma)
- Mostly children under 5
- asymptomatic abdominal mass without metastasis
- Often bilateral
Explain pathophysiology of retinoblastoma
- Which gene is mutated?
- Which cells are effected?
- Overview of mechanism?
germline mutation of RB1 gene usually present in patients
Occurs in cone precursor cells
Signalling pathways promote cell survival after loss of RB1
Describe the molecular pathology of Wilms tumour
Which genes are affected if somatic gene alterations occur [3]
Which genes are affected if germline alterations occur? [2]
Somatic gene alterations:
* In WT1, WTX and TP53 genes
* Inactivated CTNNB1 (beta catenin gene
* Epigenetic changes at IGF2/H19 locus
Germline alterations:
* In WT1 genes
* Inactivated CTNNB1 (beta catenin gene
What is the key role of WT1 gene? [1]
Ureteric branching - has key role in the epithelial induct of the metanephric mesenchyme
WT1 is critical in the key pathways for the developing kidney!
What type of genes are WT1, WTX & TP53? [1]
WT1, WTX & TP53 are Tumour Suppressor Genes
How does Rb gene work under normal function? [2]
Explain how mutation to Rb gene causes cancer [1]
Normal:
* pRb restricts the cell’s ability to replicate DNA by preventing its progression from the G1 (first gap phase) to S (synthesis phase) phase of the cell division cycle
- pRb binds and inhibits E2 promoter-binding–protein-dimerization partner (E2F-DP) dimers, which are transcription factors of the E2F family that push the cell into S phase.
- By keeping E2F-DP inactivated, RB1 maintains the cell in the G1 phase, preventing progression through the cell cycle and acting as a growth suppressor.
Pathology:
* Mutation causes no Rb1 hyperphosphorylation due to lack of binding to E2F

Which other genes are implicated in retinoblastoma? [4]
MYCN activation
MDM2 or MDM4 over-expression or amplification - leads to inactivation of TP53
Tx of retinoblastoma:
- Small tumour? [3]
- Advanced tumours [3]
Small tumours: cryotherapy, laser therapy or thermotherapy
More advanced tumours or distant disease: chemotherapy, surgery &/or radiation
Neuroblastoma:
how does it often present at diagnosis? [1]
Metastatic disease in >50% cases at diagnosis; spreads via lymphatics and blood stream
Neuroblastoma is a tumour of which body system? [1]
Which organs does it usually occur in? [2]
Tumour of the sympathetic nervous system, usually arising in the adrenal gland or sympathetic ganglia
Which oncogenes are involved with neuroblastoma? [3]
MYCN amplification, ALK & PHOX2B
What is the difference betwen molecular pathology of neuroblastoma between high risk, low risk and hereditary patients? [3]
High risk patients
* Have high MYCN amplification; ATRX & ALK mutations
* Near-diploid/near-tetraploid karyotype, complex chromosome aberrations
* Deletions in 1p and 11q
Low risk:
* Numerical chromosome gains (e.g. spontaneous chromosomes)
Hereditary
* Germline ALK mutations
How do patients with Acute Lymphoblastic Leukaemia (ALL) present [3]
Where does infiltration of ALL usually occur? [4]
- bruising or bleeding due to thrombocytopaenia
- pallor and fatigue due to anaemia
- infection due to neutropenia
- Infiltratration to the liver, spleen, lymph nodes and mediastinum common at diagnosis
In children, what are the three major types of ALL? [3]
In children ~80% are CD19+, CD10+ “B-cell precursor ALL”
Which comes first Pro-B or Pre-B? [1]
What are Pro-B and Pre-B cells characterised by on their cell surfaces? [3]
Pro-B then Pre-B
ProB cells are characterized by cell surface marker CD19+
PreB cells are characterized by cell surface markers CD19+ and CD10+
What are the distinctive cell abnormalites that often occur in Pro-B cells and Pre-B cells? [2]
There are distinctive cell abnormalities:
Pro-B (CD19+, CD10-) always have translocation of MLL gene translocated
Pre-B always have translocation of chromosomes 12 & 22
How do Pro-B ALL cells appear histologically? [1]
Lots of pre-cursor cells